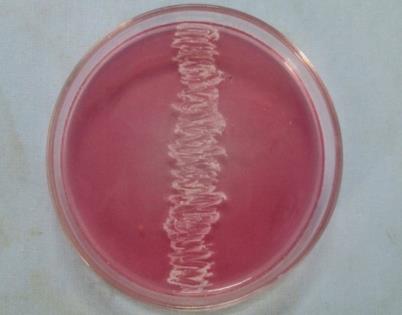

Int J Pharm Pharm Sci, Vol 7, Issue 9, 112-115Original Article
Studies on optimization of L-Asparaginase production by Arthrobacter kerguelensis VL-RK_09 isolated from Mango orchards
Rajesh Kumar Munaganti, Vijayalakshmi Muvva*, Mani Deepa Indupalli
Department of Botany and Microbiology, Acharya Nagarjuna University, Guntur 522510, A. P., India
Email: profmuvva@gmail.com
Received: 06 Jun 2015 Revised and Accepted: 06 Jul 2015
Abstract
Objectives: To optimize the cultural parameters for improved production of L-asparaginase by Arthrobacter kerguelensis VL-RK_09 isolated from Mango orchards of Vissannapet, Krishna District, A. P., India.
Methods: The strain A. kerguelensis was screened for L-asparaginase production on modified asparagine dextrose salts agar medium. L-asparaginase assay was performed as described by Peterson and Ciegler (1969) with slight modifications. Cell free broth (0.2 ml) was placed with 0.8 ml of 0.05M Tris-HCl and 1 ml of 0.04M L-asparagine and incubated for 15 min at 37 oC and liberated ammonia was determined spectrophotometrically at 500 nm by nesslerization. Attempts were made to optimize cultural parameters affecting the production of L-asparaginase by the strain.
Results: Maximal yield of L-asparaginase was recorded after 3days of incubation in asparagine dextrose salts broth with initial pH 7.0 and temperature 30 °C. Biosynthesis of L-asparaginase by the strain was improved (from initial 4.28 IU to 6.5 IU) when cultured in modified asparagine dextrose salts broth (initial pH 7.0) supplemented with 1.5% yeast extract and 2% xylose maintained at 30 ° C for 72 h. This is the first report on the production and optimization of L-asparaginase by A. kerguelensis.
Conclusion: In the present study, the optimal cultural and nutritional conditions for the production of L-asparaginase by A. kerguelensis VL-RK_09 were recorded. This is the first report on the production and optimization of L-asparaginase by A. kerguelensis and further studies on purification and characterization of the enzyme is in progress.
Keywords: Mango orchards, Arthrobacter kerguelensis, L-asparaginase.
Introduction
L-asparaginase (L-asparagine amidohydrolase, E. C. 3.5.1.1) constitutes one of the most biotechnologically and biomedically important group of therapeutic enzymes accounting for about 40% of the total worldwide enzyme sales [1]. It is a pyrimidine derivative and has long been considered as an important compound in the management of childhood acute lymphoblastic leukemia. Its antileukemic effect is related to the incapability to synthesize the asparagine from asparatic acid. It belongs to an amidase group that produces aspartic acid and ammonia by asparagine hydrolysis [2, 3]. Screening of microbial sources for L-asparaginase activity has been greatly intensified and well documented. The importance of microorganisms as L-asparaginase sources have been focused since the time it was obtained from Escherichia coli and its antineoplastic activity demonstrated in guinea pig serum [4-8]. The prompt therapeutic potential of the enzyme greatly intensified the screening several microbial species and has been well documented in E. coli [9 10], Erwinia cartovora [11, 12], Enterobacter aerogenes [13], Corynebacterium glutamicum, Candida utilis [14], Staphylococcus aureus [15] and Thermus thermophilus [16].
Actinomycetes act as potential candidates for the production of L-asparaginase. S. karnatakensis, S. venezuelae [18], Nocardia asteroides [19], S. longsporusflavus F-15 [20], S. albidoflavus [21], Streptomyces noursei MTCC 10469 [22], Nocardia levis MK-VL 113 [23] and Pseudonocardia endophytica VUK-10 [24] were proved to be potential producers of this enzyme.
Search for new serologically different L-asparaginase with a similar therapeutic effect is highly desirable to prevent the adverse reactions such as anaphylactic shock and in neutralization of drug that are associated with administration of such enzyme protein for a long duration. As very little information is available on the production of L-asparaginase by the genus Arthrobacter the present study was aimed to explore it. While screening the actinomycetes for asparaginase production, a strain with good asparaginase activity on asparagine dextrose salts agar medium was identified as Arthrobacter kerguelensis by 16S rRNA analysis. In the present study, an attempt has been undertaken to reveal the optimization of L-asparaginase production by A. kerguelensis VL-RK_09.
Materials and Methods
The strain A. kerguelensis VL-RK_09 was isolated from soils of Mango orchards located at Vissannapet, Krishna District, A. P, India on Yeast extracts malt extracts dextrose agar (ISP-2) medium by soil dilution technique. The strain was identified by polyphasic approach and the 16S rRNA gene sequence of the strain has been deposited in NCBI genbank with an accession number KJ787652. The strain was maintained on (ISP-2) agar medium at 4ºC for further study.
Screening of the strain for L-asparaginase activity
The strain A. kerguelensis was screened for L-asparaginase production on modified asparagine dextrose salts agar medium containing 1% L-asparagine and 0.03% phenol red dye [21, 25]. L-asparaginase production was observed by the change in colour of the dye from yellow to pink indicating the ability of the strain to hydrolyze L-asparagine to L-aspartic acid and ammonia.
Production profile of L-Asparaginase
For determining the production profile of L-asparginase, basal medium containing L-asparagine (nitrogen source) 1%, Dextrose (carbon source) 0.1%, K2HPO4 0.25% and MgSO4.7H2O 0.01%, pH 7.0 was inoculated with culture suspension from one week old strain maintained on ISP-2 agar medium. The inoculated flasks were incubated at 30oC for 6 days in order to estimate the growth of the strain as well as L-asparagine production at 24 h intervals. Growth was expressed in terms of dry weight of biomass (mg mL-1). L-asparaginase assay was carried out as described by Peterson and Ciegler (1969) with slight modifications [26]. Cells were removed by centrifuging the culture broth at 10000 rpm for 15 min. The pellet was removed and the cell free broth (0.2 ml) was placed with 0.8 ml of 0.05M Tris-HCl and 1 ml of 0.04M L-asparagine. After incubating the reaction mixture for 15 min at 37oC in a water bath shaker, the reaction was terminated by the addition of 0.5 ml of 15% (w/v) trichloroacetic acid. Precipitated proteins were removed by centrifugation and the liberated ammonia was determined spectrophotometrically at 500 nm by nesslerization. Tubes kept at zero time incubation served as control. Enzyme production was determined on the basis of liberation of ammonia calculated with reference to a standard curve of ammonium sulfate. One asparaginase unit (U) equals to that of the amount of enzyme which releases 1 µM of ammonia (ammonium sulfate as standard) in 1 min at 37oC. The dry weight of biomass (mg/10 ml) was recorded simultaneously by drying the cell debris collected after centrifugation in an oven at 90 °C for 24h.
Optimization of L-asparaginase production
Influence of different cultural conditions such as pH, temperature, carbon and nitrogen sources on the production of L-asparaginase was determined by growing the strain in glucose asparagine broth for 72 h.
Initial pH and temperature
Impact of pH on L-asparaginase production was examined by culturing the strain in glucose asparagine broth adjusted to pH levels varying from 5 to 10. The optimal pH achieved at this step was used for further study. To determine the optimum temperature for asparaginase production, the strain was cultured in glucose asparagine broth at different temperatures viz., 25 to 45oC for 72 h.
Carbon sources
To investigate the effect of carbon sources on L-asparaginase production by the strain, glucose asparagine broth was supplemented with different carbon sources such as starch, lactose, sucrose, xylose, mannitol, maltose, galactose and fructose each at a concentration of 1% (w/v). The carbon source which supports good yields of L-asparaginase production by the strain was chosen for further study. Influence of different concentrations of the best carbon source (1–4% w/v) on L-asparaginase production by the strain was studied and the optimal level achieved at this step was employed for further studies.
Nitrogen sources
The effect of nitrogen source was determined by amending different inorganic and organic nitrogen sources such as yeast extract, peptone, malt extract, asparagine, arginine, histidine, beef extract, tryptophan each @1% (w/v) was supplemented into glucose asparagine broth. The nitrogen source found to be good for optimal L-asparaginase production was chosen for further study. Besides, the optimal concentration of the nitrogen source (1-3% w/v) supporting high yields of L-asparaginase by the strain was determined by maintaining all other conditions at optimal levels.
Statistical analysis
Statistical data are recorded on growth of the strain and enzyme production by using One-way Analysis of Variance (ANOVA).
Results and Discussion
Identification of the strain
The strain was identified as Arthrobacter kerguelensis VL-RK_09 based on morphological, cultural, physiological, biochemical and 16S rDNA analysis.
Screening for L-asparaginase activity
Screening of L-asparaginase was carried out on Asparagine dextrose salts (ADS) agar. The production of the enzyme was evidenced by a change in colour of the dye from yellow to pink (Plate 1).
Production profile of L-asparaginase
Asparaginase is an anti-neoplastic agent, used in the therapy of lymphoblastic leukemia. It has received increased attention in recent years as food processing aid and also for application in L-asparagine biosensor for leukemia [27, 28]. Extracellular asparaginases are more advantageous than intracellular ones, since they can be produced abundantly in the culture broth under normal conditions and purified economically.
The production of an enzyme by the strain started after 24 h of growth. Maximum levels of L-asparaginase production as well as growth were observed after 72 h of incubation (fig. 1). A good correlation was found between enzyme yield and active growth of the strain. Similar results were reported for growth and L-asparaginase productivity in S. karnatakensis [18] and S. albidoflavus [21]. Maximum yields of L-asparaginase and biomass were obtained from 72 h old culture of Amycolatopsis CMU-H002 [29].
Plate 1: L-Asparaginase activity of Arthrobacter kerguelensis VL-RK_09 on ADS agar

Fig. 1: Production profile of L-asparaginase by Arthrobacter kerguelensis VL-RK_09 in modified asparagine dextrose salts broth (Values are the means of three replicates±SD)
Optimization of L-asparaginase production
Impact of different cultural conditions such as pH, temperature, carbon and nitrogen sources on the production of L-asparaginase by the strain was determined.
Impact of initial pH on asparaginase production by A. kerguelensis VL-RK_09
Studies on the influence of initial pH levels (5–10) were carried out to determine the optimal pH. Optimal production of L-asparaginase by the strain was noted at pH 7.0 (fig. 2). These findings are consistent with the results reported by Abdel-All et al. (1998) in S. phaeochromogenes FS-39 [30] and Dhevendaran and Anithakumari (2002) in Streptomyces AQB VC67 who recorded pH 7.0 as optimum for L-asparaginase production [31]. Sahu et al. (2007) also recorded optimal L-asparaginase production for S. aureofasciculus, S. chattanoogenesis, S. hawaiiensis, S. orientalis, S. canus and S. olivoviridis at pH levels between 7 and 8 [32]. Maximal yields of L-asparaginase by Nocardia levis MK-VL_113 were recorded with initial pH 7.0 [23]. In the present study, the strain showed maximum L-asparaginase production when cultured in modified asparagine dextrose salts broth for 72 h with an initial pH 7.

Fig. 2: Impact of initial pH on L-asparaginase production by Arthrobacter kerguelensis VL-RK_09 cultured in modified asparagine dextrose salts broth (Values are the means of three replicates±SD)
Effect of temperature on L-asparaginase production by A. kerguelensis VL-RK_09
The impact of temperature on production of L-asparaginase is shown in fig. 3. The optimal temperature recorded for the production of L-asparaginase by the strain was 30oC. Similar optimal temperatures were recorded in S. collinus and S. longisporusflavus F-15 for the production of L-asparaginase [18, 20]. The temperature at 30 °C favored L-asparaginase production by S. acrimycini NGP and S. ginsengisoli [33, 34]. The present study revealed that L-asparaginase production by the strain was high when grown in modified asparagine dextrose salts broth with initial pH 7.0 for 72 h at 30 oC.

Fig. 3: Effect of temperature on L-asparaginase production by Arthrobacter kerguelensis VL-RK_09 cultured in modified asparagine dextrose salts broth (Values are the means of three replicates±SD)
Effect of carbon sources on L-asparaginase production by A. kerguelensis VL-RK_09
Different carbon sources amended in modified asparagine dextrose salts broth employed for determination of their effect on L-asparaginase production by the strain. As compared to the other carbon sources tested, L-asparaginase production by A. kerguelensis was high in modified asparagine dextrose salts broth containing xylose (fig. 4). Studies on the effect of different levels of xylose (1–4% w/v) revealed that optimal yields of L-asparaginase were recorded in medium amended with xylose @ 2% (Fig.5). Further increase in concentration led to decline in the production of the enzyme. The optimal level of carbon source for L-asparaginase production by S. phaeochromogenes FS-39 was 2% glycerol, while it was 1.5% starch for S. longsporusflavus F-15 [30, 20]. High levels of L-asparaginase production were found by inoculating the strain in modified asparagine dextrose salts broth with xylose (2%) and incubated at 30 oC for 72h.
Effect of nitrogen sources on L-asparaginase production by A. kerguelensis VL-RK_09
L-asparaginase production by the strain was found to vary with different nitrogen compounds tested (fig. 6). Among them, yeast extracts favoured high yields of L-asparaginase followed by tryptophan. Yeast extract was reported as an excellent nitrogen source for L-asparaginase production by Erwinia aroideae and E. carotovora EC-113, respectively [35, 11].
The study of different levels of yeast extract (1–3% w/v) revealed that the production of L-asparaginase by the strain was high in medium containing 1.5% yeast extract (fig. 7). In S. albidoflavus 2% yeast extract was recorded as optimal nitrogen source for L-asparaginase production by Narayana et al.,(2008) [21]. In the present study, the optimal conditions for the synthesis of L-asparaginase by the strain included modified asparagine dextrose salts broth (initial pH 7.0) supplemented with 1.5% yeast extract and 2% xylose maintained at 30 ° C for 72 h.

Fig. 4: Impact of different carbon sources on L-asparaginase production by Arthrobacter kerguelensis VL-RK_09
(Values are the means of three replicates±SD)

Fig. 5: Impact of concentration of xylose on L-asparaginase production by Arthrobacter kerguelensis VL-RK_09
(Values are the means of three replicates±SD)

Fig. 6: Impact of nitrogen sources on L-asparaginase production by Arthrobacter kerguelensis VL-RK_09
(Values are the means of three replicates±SD)

Fig. 7: Impact of concentration of yeast extract on L-asparaginase production by Arthrobacter kerguelensis VL-RK_09 (Values are the means of three replicates±SD)
Conclusion
In the present study, the optimal cultural and nutritional conditions for the production of L-asparaginase by A. kerguelensis VL-RK_09 were recorded. Biosynthesis of L-asparaginase by the strain was improved (from initial 4.28 IU to 6.5 IU) when cultured in modified asparagine dextrose salts broth (initial pH 7.0) supplemented with 1.5% yeast extract and 2% xylose maintained at 30 ° C for 72 h. This is the first report on the production and optimization of L-asparaginase by A. kerguelensis and further studies on purification and characterization of the enzyme are in progress.
Acknowledgement
The authors are thankful to UGC for providing the financial assistance to carry out the research work and also to the Department of Botany and Microbiology for providing the laboratory facilities.
CONFLICT OF INTERESTS
Declared None
References
- Warangkar SC, Khobragade CN. Purification, characterization, and effect of thiol compounds on activity of the Erwinia carotovora L-asparaginase. Enzyme Res 2010;1:1-10.
- Wriston JC, Yellin T. L-asparaginase: a review. Adv Enzimol 1973;39:185.
- Capizzi RL, Poole M, Cooper MR, Richards F, Stuart JJ, Jakson DV, et al. Treatment of poor risk acute leukaemia with sequential higdone ARA-C and asparaginase. Blood 1984;63:649-700.
- Broome JD. Evidence that the L-asparaginase activity of guinea pig serum is responsible for its antilymphoma effects. Nature 1961;191:1114-5.
- Mashburn LT, Wriston JC. Tumor inhibitory effect of L-asparaginase from Escherichia coli. Arch Biochem Biophys 1964;105:450-2.
- Roberts J, Prager MD, Bachynsky N. The antitumor activity of E. coli L-asparaginase. Cancer Res 1966;26:2213-7.
- Schwartz JH, Reeves JY, Broome JD. Two L-asparaginase from E. coli and their action against tumors. Proc Natl Acad Sci 1966;56:1516-9.
- Boyse AE, Old LJ, Campbell HA, Mashburn LT. Suppression of murine leukaemia of various types: comparative inhibition activities of guinea pig serum L-asparaginase and E. coli. J Exp Med1967;125:17-31.
- Derst C, Wehner A, Specht V, Rohm KH. States and functions of tyrosine residues in Escherichia coli asparaginase. Eur J Biochem 1994;224:533-40.
- Mercado L, Arenas G. Escherichia coli L-asparaginase induced phosphorylation of endogenous polypeptide in human immune cells. Sangre 1999;44:438-42.
- Maladkar NK, Singh VK, Naik SR. Fermentative production and isolation of L-asparaginase from Erwinia cartovora EC-113. Hind Antibiot Bull 1993;35:77-86.
- Aghaiypour K, Wlodowes A, Lubkowski J. Structural basis for the activity and substrate specificity of Erwinia chrysanthemi L-asparaginase. Biochem 2001;40:5655-64.
- Mukherjee J, Majumadar S, Scheper T. Studies on nutritional and oxygen requirements for production of L-asparaginase by Enterobacter aerogenes. Appl Microbial Biotechnol 2000;53:180-4.
- Kil JO, Kim GN, Park I. Extraction of extracellular L-asparaginase from Candida utilis. Biosci Biotechnol Biochem 1995;59:749-50.
- Muley RG, Sarker S, Ambedkar S, Nail SR. Influence of alkali treated corn steep liquor containing medium on protein production by Staphylococcus aureus. Folia Microbiol 1998:43:31-4.
- Prista AA, Kyridio DA. L-asparaginase of Thermus thermophilus:purification, properties and identification of essential amino acids for catalytic activity. Mol Cell Biochem 2001:216:93-101.
- DeJong PJ. L-asparaginase production by Streptomyces griseus. Appl Microbiol 1972:23:1163-4.
- Mostafa SA, Salma MS. L-Asparaginase producing Streptomyces from the soil of Kuwait. Zentralbl Bakteriol Naturwiss 1979:134:325-34.
- Gunasekaran S, McDonald L, Manavathu M. Effect of culture media on growth and L-asparaginase production in Nocardia asteroids. Biomed Lett 1995;52:197-201.
- Abdel-Fatah MK. Studies on the asparaginolytic enzymes of Streptomycetes. Culture conditions for the production of L-asparaginase enzyme from Streptomyces longsporusflavus (F-15) strain. Egypt J Microbiol 1996:30:247-60.
- Narayana KJP, Kumar KG, Vijayalakshmi M. L-asparaginase production by Streptomyces albidoflavus. Indian J Microbiol 2008:48:331-6.
- Selvakumar D. Study of L-asparaginase production by Streptomyces noursei MTCC 10469, isolated from marine sponge Callyspongia diffusa. Iran J Biotech 2011;9:102-8.
- Kavitha A, Vijayalakshmi M. A Study on L-Asparaginase of Nocardia levis MK-VL 113. Sci World J 2012:1-5. doi:10.1100/2012/160434. [Article in Press]
- Usha Kiranmayi M, Sudhakar P, Vijayalakshmi M. Production and optimization of L-asparaginase by an actinobacterium isolated from Nizampatnam mangrove ecosystem. J Environ Biol 2014;35:799-805.
- Priya PM, Radhakrishnan M, Balagurunathan M. Production and optimization of L-asparaginase from Streptomyces sp(TA22) isolated from Western Ghats, India. J Chem Pharm Res 2011;3:618-24.
- Peterson RE, Ciegler A. L-asparaginase production by various bacteria. Appl Microbiol 1969;18:64-7.
- Tareke E, Rydberg P, Karlsson P, Eriksson S, Tornqvist M. Analysis of acrylamide, a carcinogen formed in heated foodstuffs. J Agric Food Chem 2002;50:4998-06.
- Verma N, Kumar K, Kaur G, Anand S. E. coli K-12 asparaginase-based asparagine biosensor for leukemia. Artif Cells Blood Substitutes Immobilization Biotechnol 2007;35:449-56.
- Khamna S, Yokota A, Lumyong S. L-asparaginase production by actinomycetes isolated from some Thai medicinal plant rhizosphere soils. Int J Integr Biol 2009;6:22-6.
- Abdel-All SM, Abdel-Fatah MK, Khalil A. Studies on the asparaginolytic activity of the brown-pigmented Streptomycetes. J Drug Res 1998;22:171-94.
- Dhevendaran K, Anithakumari YK. L-asparaginase activity in growing conditions of Streptomyces spp. associated with Therapon jarbua and Villorita cyprinoids of Veli lake, South India. Fish Technol 2002;39:155.
- Sahu MK, Sivakumar K, Poorani E, Thangaradjou T, Kanna L. Studies on L-asparaginase enzyme of actinomycetes isolated from estuarine fishes. J Environ Biol 2007;28:465-74.
- Selvam K, Vishnupriya B. Partial purification and cytotoxic activity of L-asparaginase from Streptomyces acrimycini NGP. Int J Res Pharm Biomed Sci 2013;4:859-69.
- Deshpande N, Choubey P, Agashe M. Studies on optimization of growth parameters for L-Asparaginase Production by Streptomyces ginsengisoli. Sci World J 2014;1-6. doi:10.1155/2014/895167. [Article in Press]
- Liu FS, Zajic JE. L-Asparaginase synthesis by Erwinia aroideae. Appl Microbiol 1972;23:667-8.